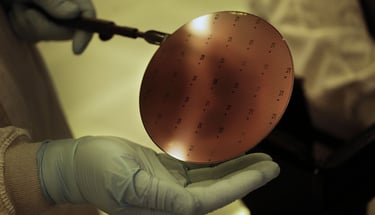

La réponse du Pentagone à la Chine !
Suite aux restrictions annoncées par la Chine, le Pentagone s'organise et décide de recycler le gallium
NEWS

Les restrictions imposées par la Chine obligent le Pentagone à s'adapter et à conclure des contrats de récupération de gallium
Rappelez-vous les amis, dans notre article du 5 juillet (La Chine fait encore des siennes ! | Pax Pc News), nous vous expliquions que la Chine restreignait les exportations de matériaux essentiels à la fabrication de puces, le gallium et le germanium, dans le cadre de nouvelles lois de politique étrangère. Les nouvelles règles d'exportation exigent en effet des entreprises chinoises l'obtention d'une licence d'exportation pour ces métaux, ainsi que pour les produits les contenant, dès le 1er août 2023. Pour rappel, la Chine est le plus grand producteur mondial de gallium et de germanium, et de loin ! Cette nouvelle mesure est le résultat de la guerre commerciale technologique en cours avec les États-Unis et l'Europe et va évidemment entraîner des conséquences rapides !
Écrivez votre texte ici ...
C'est vrai que le Pentagone dispose de réserves de germanium, mais il n'en possède pas de gallium, qu'il prévoit désormais de récupérer à partir de déchets. Le gallium est utilisé dans diverses applications du Pentagone, notamment les radars, les télécommunications et les puces de puissance. C'est un métal très important pour le Département de la Défense ! Il joue en effet un rôle crucial dans les systèmes radar embarqués de la Marine pour la défense aérienne et antimissile, ainsi que dans les systèmes radar terrestres de l'Armée et des Marines pour l'identification des roquettes, de l'artillerie, des mortiers, des missiles de croisière, ainsi que des drones aériens, pilotés et non pilotés.
Ils vont utiliser le "Defense Production Act" (DPA, une loi fédérale américaine qui aide à financer des secteurs industriels essentiels pour la sécurité nationale) pour donner la priorité aux contrats d'ici la fin de l'année, en mettant l'accent sur la récup' de gallium dans d'autres déchets de produits. Apparemment, c'est plus rapide de récupérer ce métaux plutôt que de l'extraire des mines, une méthode qui n'a pas encore été financée par le DPA. Le gallium recyclable peut être récupéré des déchets de la fabrication des plaquettes de semi-conducteurs et des appareils usagés ou défectueux. Ils le raffinent ensuite pour en faire des composants électroniques..
Face aux restrictions de la Chine, les autres pays doivent s'adapter et le recyclage du gallium paraît être une bonne idée ! Pour rappel, la Chine détient quasiment 94% de la production mondiale (les boss !) de gallium et 60% de celle de germanium. Ils ont gardé les coûts super bas, donc c'est plus cher de l'extraire ailleurs. Ça pourrait augmenter les prix et perturber la production de certains composants au début, mais à long terme, ça pourrait pousser d'autres pays à se mettre à exploiter ces métaux pour faire de la concurrence à la Chine et réduire par conséquent notre dépendance..
source photo : Bloomberg




source : Tom's Hardware
Et bien, c'est déjà chose faite, car suite à ces restrictions imposées par la Chine, le Département de la Défense des États-Unis prévoit de conclure un contrat de récupération de gallium avec des entreprises américaines ou canadiennes très rapidement..


#Chine #Gallium #Germanium #Pentagone #IndustrieSemiConducteurs


